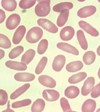

Blood Films Flashcards
1
Q
Target cells

A
- Sickle cell/thalassaemia
- IDA
- Hyposplenism
- Liver disease
2
Q
‘Tear-drop’ poikilocytes

A
- Myelofibrosis
3
Q
Spherocytes

A
- Hereditary spherocytosis
- Autoimmune haemolytic anaemia
4
Q
Basophilic stippling

A
- Lead poisoning
- Thalassaemia
- Sideroblastic anaemia
- Myelodysplasia
5
Q
Howell-Jolly bodies

A
- Hyposplenism
6
Q
Heinz bodies

A
- G6PD deficiency
- Alpha-thalassaemia
7
Q
Schistocytes (helmet cells)

A
- Intravascular haemolysis
- Mechanical heart valve
- DIC
8
Q
‘Pencil’ poikilocytes
A
- IDA
9
Q
Burr cells (echinocytes)

A
- Uraemia
- Pyruvate kinase deficiency
10
Q
Acanthocytes

A
- Abetalipoproteinaemia
11
Q
Hypersegmented neutrophils
A
- Megaloblastic anaemia


